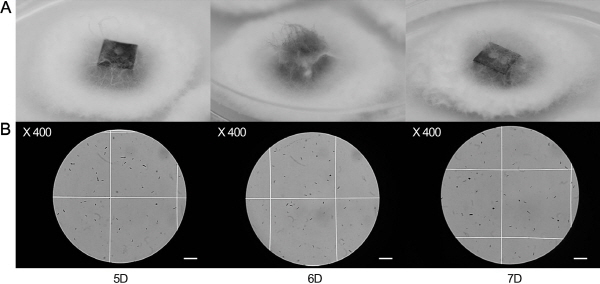
http://static.apub.kr/journalsite/sites/kshs/2015-033-06/N0130330611/images/figure_KSHS_33_06_11_F1.jpg

서 언
재료 및 방법
식물재료
접종원 준비
In vitro 접종 및 발병도 조사
기내검정체계
토양 접종에 의한 품종 별 저항성 검증
통계분석
결과 및 고찰
기내검정체계 확립
저항성 품종 선별
토양 저항성 검정
서 언
우리나라의 백합은 2013년 통계 기준 전년 대비 7.3% 재배면적이 감소하였으나 절화 수출액의 32.5%를 차지하는 등 화훼 수출산업에 있어서 중요한 위치를 차지하고 있다(MAFRA, 2014). 주로 비닐하우스나 온실에서 재배되는 백합은 그 재배환경으로 인해 뿌리나 구근의 부패병에 많이 노출되어 과다한 농약사용이 문제시되고 있는 것이 현실이다(Lebiush-Mordechai et al., 2014). 구근으로 번식하는 백합은 꽃 재배기간뿐만 아니라 구근의 증식, 보관 기간에도 Penicillium sp.와 Fusarium oxysporum f. sp. lilii(Fol)균에 인한 감염으로 절화나 종구의 생산량과 품질에 치명적인 저하가 발생한다(Loffler and Rumine, 1991). 이 구근부패병은 주로 종구나 지하부 줄기에서 감염이 일어나는데, 연작지 사질토에서 발생이 심하고 주로 토양으로부터 전염이 된다. 구근표면에 갈색 부정형 병반이 생기며, 심하면 구근 전체가 갈색으로 변하여 썩고, 계속 진전되면 인편이 탈락하게 된다(Komada, 1975). 외관상으로는 아랫잎부터 점차 떨어져버리고 포기 전체가 죽어가기도 한다. 고사한 줄기의 지제부위에는 병원체의 균사가 하얗거나 붉은색으로 자라나 있는 것을 볼 수 있다. 주로 정식 전에 토양해충방제를 철저히 하고 작업 중에 상하지 않도록 하여 상처부위를 통한 침입을 예방하는 등의 방법으로 피해 정도를 최소화하고 있다. 그러나 이러한 방법보다도 더욱 효율적으로 구근부패병을 방제하기 위해서는 구근부패병에 대한 저항성이 있는 품종을 선별하여 재배하는 것이 중요하며, 이를 위하여 각 품종의 구근부패병 저항성 정도를 진단하기 위한 간편하고 민감한 검정방법이 필요하다.
인위적인 Fol균 접종에 의한 백합 품종들의 저항성 연구는 Straathof et al.(1993)에 의해 보고된 바 있는데, 이들은 저항성 지수를 6단계로 나누어 제시하였으며 시험한 아시아틱 백합 16품종들을 그 기준에 맞추어 분류하였다. 그 이후에도 Straathof and Van Tuyl(1994)은 아시아틱 백합, 나팔백합, 오리엔탈 백합으로 각각 나누어 구근부패병에 대한 저항성을 분석하여 새로운 저항성 품종을 육성하기 위한 프로그램에 활용한 바 있다.
이들의 실험에 주로 사용된 검정법은 Fol균을 배양하여 토양에 섞은 후 백합 인편을 심고, 8주 후(Loffler et al., 1995; Straathof et al., 1993) 혹은 12주 후(Prados-Ligero et al., 2008) 수확하여 정상토양에 옮겨 심은 다음 발병을 지켜 보는 방법을 취하였다. 이렇게 포장에서 실험을 하게 되는 경우 저항성 검정에 소요되는 시간과 노력, 공간이 과하게 요구되어 효율적인 검정이 이루어지는 것이 어렵고, 시험 시기 등 환경에 따라 서로 다른 결과들이 도출될 수 있기 때문에 그 실효성이 낮은 문제점 등이 있다. 일찍이 Jung et al.(2008)은 포도 잿빛곰팡이병에 관여하는 Botrytis cinerea를 이용하여 80종의 포도 유전자원에 대한 저항성 판별을 위한 기내검정법을 제시하였고, Lee et al.(2011)은 정확하고 빠른 키다리병 품종 저항성 검정을 위하여 기내에서 검정하는 시스템을 개발하였다. Fusarium fujikuroi CF283으로 72개 품종에 대한 저항성을 검정하였고 포장저항성과 비교하여 기내유묘검정법의 유효성을 보고하였다.
본 실험에서는 Fol균에 의해 감염되는 백합의 구근부패병에 대한 저항성 또는 민감성 여부를 환경의 영향을 받지 않고 보다 단기간 내에 판별하기 위하여 기내배양 중인 식물체를 이용한 기내검정법을 개발하고자 하였다. Fol의 접종 농도, 배양 조건, 접종 시간, 접종 후 식물체 배양 시간 등에 따른 병징의 발달을 점검하여 품종 별 저항성 지표를 활용하여 분류하였으며, 이 자료는 향후 분자마커를 이용한 저항성 품종 판별 기술과 접목하여 백합 품종 육성에 활용하고자 한다.
재료 및 방법
식물재료
본 실험에 사용한 백합 품종은 실험실에서 배양 중에 있는 아시아틱 백합(‘Reinesse’, ‘Black out’, ‘Best seller’, ‘Royal surprise’, ‘Yellow ace’, ‘Red ticklers’, ‘Red velvet’, ‘Farfalla’, ‘Pink pagoda’, ‘Connecticut king’, ‘Painted pixie’, ‘Butter pixie’, ‘Lavendel’, ‘Petit pink’, ‘Disco’, ‘Sungod’, ‘Suncrest’, ‘Yellow sun’, ‘Fantasy1’), 오리엔탈 백합(‘Acapulco’, ‘Stargazer’, ‘ConAmore’, ‘Casablanca’, ‘Marco polo’, ‘Pesaro’, ‘Siberia’, ‘Sorbonne’, ‘Carmen’), 오리엔탈-트럼펫 백합(‘Trophey’, ‘Anastasia’, ‘Canca d’Or’), 국내자생나리(‘대만나리’, ‘솔나리’, ‘하늘나리’, ‘참나리’, ‘털중나리’, ‘날개하늘나리’, ‘땅나리’)를 포함하여 총 38종을 사용하였다. 여러 가지의 실험조건을 확립하기 위한 대조구는 오리엔탈계인 ‘Siberia’를 사용하였다. 대부분의 상업용 품종은 구근을 구매하여 사용하였으며, 국내자생나리는 본 연구실에서 수행하였던 자생나리 종구 대량번식 과제 수행 시에 확보한 구근이다. 모든 백합 품종들은 구근의 증식을 위해 인편 기부에 1-2번 날카로운 상처를 준 다음 MS 염농도를 2배로 설정하고 9% sucrose와 0.8% gelite를 첨가시킨 배지에 치상하여 구근을 대량으로 확보하는 방법(Jung et al., 1996)을 이용하였다. 증식시킨 구근을 다음과 같은 MS 기본배지(MS salt, 3% sucrose, 0.1% myo-inositol, 0.8% agar, pH5.8)에 치상한 후 23 ± 2°C, 16시간 광조건(광도 40μmol・m-2・s-1)의 배양실에서 배양한 후 얻어진 식물체들에서 잎과 인편을 각기 채취하여 본 실험의 기본 재료로 사용하였다.
접종원 준비
농촌진흥청 농업유전자원센터(Korea Agricultural Culture Collection, KACC)에서 Fusarium oxysporun f. sp. lilii (KACC47525)를 분양 받아서 실험을 진행하였다. 균주는 potato dextrose agar(PDA, Becton, Dickinson and Co., USA) 배지에서 7일간 배양한 균총으로부터 균사조각을 떼어 직경 13cm 페트리디쉬에 4개씩 올려놓고 25°C, 암조건에서 5, 6, 및 7일간 각각 배양하였다. 해당 일수 별 배양 균주에 10mL 멸균수를 넣고 현탁하였다. 멸균된 도말봉으로 포자를 긁어 모으고 2겹의 거즈를 이용하여 균사를 제거하고 걸러진 포자현탁액으로 접종원을 준비하였다. 포자현탁액의 포자농도는 혈구계를 사용하여 광학현미경 하에서 메틸렌블루로 염색 후 조사하였으며, 멸균수로 1.0 × 103, 1.0 × 104, 및 1.0 × 105spores・mL-1의 농도로 각각 희석하여 사용하였다.
In vitro 접종 및 발병도 조사
백합 기내식물체로부터 잎을 채취하여 1.5 × 2.0cm2 크기로 절단하여 멸균수로 절단면과 배지 잔여물을 깨끗이 세척한 뒤, 포자 농도 0, 1.0 × 103, 1.0 × 104, 및 1.0 × 105spores・mL-1의 포자현탁액 3mL이 각각 분주된 Tissue Culture Testplate (SPL Life Sciences Co.)에 침지하여 25°C, 암조건에서 22시간 접종을 진행하였다.
평균 생체중 5g 정도의 기내배양구에서 실험에 사용할 0.3 × 0.6 × 1.4cm3 크기의 인편을 채취하여 접종시료로 사용하였다. 멸균수로 절단면과 배지 잔여물을 깨끗이 제거한 뒤, 잎 절편 접종과 동일한 과정으로 실험을 진행하였다.
병원균 접종이 끝난 잎과 인편의 절편체는 0.6% 한천배지에 치상하여 발병지수를 기록하였으며, 이때 배양환경을 온도 25°C, 습도 50%, 16시간 광조건(광도 40μmol・m-2・s-1)을 유지하였다. 발병조사는 접종 후 배양 3, 5, 7일 후 절편체의 갈변, 고사, 부패 정도를 멸균수(포자농도 0)에 침지한 대조구와 비교, 판별하여 나타내었다. 발병지수는 1 = 무병징 또는 건전, 2 = 잎, 인편 가장자리의 갈변, 3 = 잎, 인편의 1/2 갈변 진행 및 부분적인 부패 시작, 4 = 잎, 인편의 전체 갈변 및 1/2 부분 부패 진행, 5 = 잎, 인편의 전체적인 부패, 6 = 병원균 균사 자람을 동반한 부패 등 6단계로 나누었다(Straathof et al., 1993). 한 처리당 10개의 샘플을, 각 처리 별로 5번의 반복 실험을 수행하였다.
모든 실험은 시료의 오염과 병원균의 외부전염을 피하기 위하여 독립된 클린벤치에서 수행하였으며 접종 후 잎과 인편의 배양 역시 독립된 배양공간에서 수행하였다.
기내검정체계
구근부패병 저항성 품종을 선발하기 위한 효율적인 기내검정체계의 조건들을 확립하기 위하여 오리엔탈 백합 ‘Siberia’를 공시하였다. 앞의 설명에서와 같이 잎 절편과 인편 접종법에 의하여 실험을 수행하였고, 3일, 5일, 및 7일 후에 병의 진행을 관찰하였다. 또한 ‘Siberia’를 통하여 확립한 기내검정법을 기내배양 백합 38종에 적용하여 민감성과 저항성으로 선별하였다. 그 중에 구근부패병에 저항성으로 판별된 14품종을 선별하여 잎, 인편 절편체에 접종한 후 구근부패병 저항성 품종인 ‘Oryun’의 인편을 대조구로 하여 각각 7일, 14일 동안 관찰하며 발병 양상을 확인하였다.
토양 접종에 의한 품종 별 저항성 검증
기내검정을 통해 선별된 저항성 3품종과 민감성 3품종을 포장 저항성과 비교분석을 위해 토양 접종을 실시하였다. 기내배양 중에 있던 공시된 백합 배양구를 배지 성분을 제거하기 위해 5분간 멸균수로 씻어내었다. 원예용상토(부농)를 고압멸균기를 이용하여 121°C에서 15분 동안 멸균한 후 포자 현탁액을 1.0 × 104spores・g-1 농도로 접종하여 하루 동안 둔 후, 지름 11cm, 높이 10cm 포트에 담고 각 품종 별로 배양구를 파종하였다. 생장상[온도 24/20°C(주간/야간), 습도 50%, 16시간 광조건(광도 40μmol・m-2・s-1)]에서 14일 간 인편의 감염 정도(1 = 무병징 또는 건전, 2 = 인편 가장자리의 갈변, 3 = 인편의 1/2 갈변 진행 및 부분적인 부패 시작, 4 = 인편의 전체 갈변 및 1/2 부분 부패 진행, 5 = 인편의 전체적인 부패, 6 = 병원균 균사 자람을 동반한 부패)를 확인하였다.
통계분석
각 실험의 결과에 대해 유의성을 판단하기 위하여 Excel (Microsoft office) 프로그램을 이용하여 student’s t-test를 통해 유의성을 검정하였다. 기내배양품종과 토양접종 실험은 저항성품종과 민감성품종의 발병지수에 대해 유의성을 검정하였고, 백합의 잎과 인편에 접종하여 비교한 실험은 잎과 인편의 발병지수에 대해 유의성을 검정하였다. 모든 검정은 95% 유의수준을 기준으로 검정하였다.
결과 및 고찰
기내검정체계 확립
백합 구근부패병의 병원균인 Fol에 의해 감염되어 나타나는 증상은 오리엔탈 백합과 아시아틱 하이브리드 백합간의 차이가 거의 없고 Easter 백합에서도 유사하게 나타난다(Bald et al., 1983). 본 연구에서는 구근부패병에 중간 정도의 민감성 품종으로 분류되어 있는 오리엔탈 백합 ‘Siberia’ (Prados-Ligero et al., 2008)를 공시품종으로 하여 저항성 백합을 선발하기 위한 기내검정체계를 확립하는 실험을 수행하였다. Fol균을 25°C, 암조건에서 5, 6, 및 7일 동안 배양하여 포자현탁액을 만들어 혈구계로 관찰해본 결과 6일 배양한 병원균의 포자가 대부분 격막이 없고, 난형 또는 콩팥모양이었으며, 크기가 5-10 × 2-5μm로 소형분생포자로 형성되어(Fig. 1) 접종하기 가장 적합하다고 판단하였다(Ham et al., 2006). Straathof and Van Tuyl(1994)은 백합 구근부패병에 대한 식물체의 반응을 6단계로 나눈 바 있으며 그 기준에 따라 강한 저항성, 중간 저항성, 민감성으로 품종들을 분류하였고, 이에 따라 본 실험에서는 Fol균 접종 후 나타나는 발병 지수를 6단계로 나누어 지수 1은 구근부패병의 증상이 없이 대조구와 비슷한 수준, 지수 2는 잎 절편체의 가장 자리에서 갈변의 시작이 보이는 경우, 지수 3은 잎의 중앙 부분까지 갈변이 진행되고 일부 고사가 보이는 경우, 지수 4는 잎의 전반적인 면이 갈변되면서 부패 증상이 나타나기 시작하는 경우, 지수 5는 전반적으로 고사된 경우, 및 지수 6은 완전히 고사하여 균사체가 자라는 부패 증상을 동반하는 경우로 나누어 육안으로 면밀히 관찰 후 표기하였다. 현미경적 관찰에 의한 판별 이외에 병원균의 배양일수 별 백합 절편체에 대한 발병 정도를 관찰 결과, 5일 배양한 병원균으로 접종한 절편체들은 초기에 1정도의 발병 지수를 나타내며 대조구와 큰 차이를 보이지 않았고, 5일 후부터 고사되는 증상 없이 절편체에 병원균이 자라 7일 뒤엔 4정도의 발병 지수로 나타났고, 포자현탁액 농도 별 차이가 거의 나타나지 않았다(Fig. 2A). 7일 배양한 병원균으로 접종한 절편체에서도 1.0 × 103spores・mL-1의 농도에서 5일 동안 발병 지수가 대조구와 비슷하게 지수 1정도였고, 7일 후엔 잎의 반 정도가 고사가 진행되어 발병 지수 3을 나타냈다. 1.0 × 104 spores・mL-1, 1.0 × 105spores・mL-1의 농도에서는 초기부터 3이상의 발병 지수를 나타내었다(Fig. 2C). 반면 6일 배양한 병원균으로 접종한 절편체들은 포자 현탁액 농도 별로 대조구와는 다르게 구근부패병 초기 증상인 잎이 갈변되기 시작하는 증상이 나타났고, 5일이 지나고 나서는 절편체에 병원균이 발생하는 것을 확인할 수 있었다. 1.0 × 105spores・mL-1 농도에서는 5일부터 지수 5정도로 잎 절편체 전체적으로 고사가 진행되었다(Fig. 2B). 이 결과로 백합의 잎과 인편을 대상으로 한 기내검정법에 가장 적절한 병원성을 나타내는 Fol균의 배양 일수는 6일 임을 알 수 있었다. 더불어 Fol균의 식물체 접종 방법으로 침지법과 스프레이법을 수행하여 결과를 비교하여 본 결과, 스프레이법에 비해 침지법이 절편체에 균일하게 접촉되면서 처리도 안전하고 용이하였다(결과 미제시). Lee et al.(2011)은 키다리병 저항성 벼 품종 선발을 위하여 Fusarium fujikuroi CF283 접종 시에 침지법을 이용하였고, Jung et al.(2008)은 포도 잿빛곰팡이병 저항성 판별을 위하여 피펫 접종을 수행하였다. 이와 같이 병원균 접종법은 대상 작물 별, 대상 절편체 별 다양하며 이는 실험을 통하여 구명하여야 할 것으로 본다.
병원균의 접종 농도에 따른 발병 정도를 확인해보면 6일 간 배양한 Fol의 포자 현탁액 농도를 1.0 × 103spores・mL-1의 농도로 접종한 잎 또는 인편의 절편체는 초기에 대조구와 별 차이가 없었으며, 접종 후 5일 이후부터 조금씩 차이가 나기 시작하였다. 1.0 × 104spores・mL-1의 농도에서는 절편체의 병 발달이 대조구 대비 뚜렷하게 나타나는데, 특히 5일 후부터는 차이가 확연해지면서 7일이 지나자 절편체가 고사되는 부위에 병원균이 자라는 것을 확인할 수 있었다(Fig. 2B). 1.0 × 105spores・mL-1 농도의 포자현탁액에 침지했던 절편체들은 접종 후 1일 후부터 대조구와 차이가 나기 시작하여 7일 정도 지나자 잎 절편체는 완전히 고사된 잎도 있었고, 고사된 부위에서 병원균이 많이 자라나는 것을 확인할 수 있었다(Fig. 2B). 한편 ‘Siberia’의 인편은 잎과 비슷한 양상을 보였으나 잎 절편체에서 나타난 증상처럼 발병 진행에 따른 단계적인 증상을 수치화하기 어려웠으며, 인편 표피에서 갈변이나 부패 등의 병징 없이 곧바로 병원균이 자라나는 현상이 확인되어 기내검정법의 대상 재료로는 적당하지 않음을 알 수 있었다(Fig. 2D). Senthil et al.(2013)은 Phytophthora palmivora에 의해 발생되는 카사바의 괴경부패병에 대한 기내검정체계를 확립하기 위하여 카사바의 잎, 괴경, 줄기를 공시재료로 시험한 결과 잎이 괴경과 줄기에 비해 균에 대한 반응이 더 민감하게 나타나 저항성 선발을 위한 검정체계에 가장 적당한 재료임을 보고한 바 있다. 본 실험에서도 백합의 잎과 인편을 재료로 접종한 결과 인편보다는 잎에서 반응이 더 민감하게 나타나 잎이 기내검정체계에 적합하다고 생각되나, 구근부패병이 토양에서 전염되어 구근에 주로 감염되는 것을 고려하면 인편에 대한 실험도 병행하여 제시되어야 할 것으로 본다.
위의 실험결과들을 종합하여 볼 때, 6일 간 PDA에서 배양한 Fol균을 1.0 × 104spores・mL-1의 농도로 잎 절편체에 22시간 동안 25°C, 암조건에서 침지법으로 접종한 후 7일 동안 발병 지수를 기록하여 백합 구근부패병 저항성 정도를 검정할 수 있을 것으로 보인다.
저항성 품종 선별
기내검정방법으로 확립한 조건을 바탕으로 ‘Siberia’ 포함 38종의 disease-free 기내식물체를 사용하여 Fol균에 대한 반응을 구명하였다(Fig. 3). 실험 결과, 잎 절편체의 일부분에서만 발병 증상이 나타나며, 저항성 품종이라고 알려진 ‘Connecticut king’(Loffler et al., 1995; Straathof et al., 1993)의 발병지수(1.97)보다 낮은 발병도를 보인 14품종(‘Reinesse’, ‘Acapulco’, ‘Stargazer’, ‘Black out’, ‘Best seller’, ‘Royal surprise’, ‘Yellow ace’, ‘Red ticklers’, ‘Red velvet’, ‘Trophey’, ‘Fafalla’, ‘대만나리’, ‘솔나리’, ‘Pink pagoda’)을 저항성 품종으로 선별하였고, 접종 7일 후에 잎 절편체의 전반적인 면이 갈변되면서 부패 증상이 나타나는(발병지수 3이상) 10품종(‘Painted pixie’, ‘Anastasia’, ‘Lavendel’, ‘Petit pink’, ‘Disco’, ‘Marco polo’, ‘Pesaro’, ‘하늘나리’, ‘Fantasy1’, ‘땅나리’)을 민감성 품종으로 선별하였다. 그 외 13품종(‘Butter pixie’, ‘Canca d’Or’, ‘Sungod’, ‘ConAmore’, ‘Suncrest’, ‘Casablanca’, ‘Siberia’, ‘Yellow sun’, ‘Sorbonne’, ‘Carmen’, ‘참나리’, ‘털중나리’, ‘날개하늘나리’)은 구근부패병에 중간 정도의 저항성(발병지수 2이상 3이하)을 나타낸다고 선별하였다. 통계분석결과 유의수준 5%에서 귀무가설을 기각할 수 있으므로 group A 품종과 group B 품종의 저항성 정도 차이가 있는 것으로 나타났다. Straathof and Van Tuyl(1994)은 ‘Casablanca’, ‘Stargazer’, ‘대만나리’를 민감성 품종으로 분류하였고, Loffler et al.(1995)의 결과에도 ‘Stargazer’가 민감성 품종으로 보고된 바 있다. 위에 보고된 실험들은 균을 접종한 토양에 구를 심어 발병 정도를 측정한 결과이므로 기내에서 진행된 검정법으로 인한 차이인지 공시재료 부위에 따른 차이인지 혹은 다른 요소에 의한 차이인지는 더 연구가 필요할 것으로 생각된다.
1차 실험결과 나온 14품종의 저항성이 재현되는지 정확하게 판단하기 위하여 공시재료 잎과 인편을 동시에 사용하였고, 구근부패병 저항성 품종으로 알려진 ‘Oryun’의 인편을 대조구로 하여 발병 정도를 비교하는 실험을 진행하였다. 잎은 7일간 발병 정도를 확인하였고, 잎에 비해 발병 증상이 늦게 나타나는 인편은 14일 동안 관찰하였다. 그 결과 1차 실험에서 나타났던 저항성 정도가 유사하게 재현되었으며 잎과 인편 공히 비슷한 양상으로 나타났다. 대조구로 사용한 저항성 품종 ‘Oryun’은 발병이 거의 되지 않음을 확인할 수 있었다(Fig. 4). 인편과 잎의 병징 발달에서 발병지수가 0.5이상 차이가 나는 ‘Stargazer’(발병지수 차이: 0.53), ‘Red ticklers’ (발병지수 차이: 0.51), ‘대만나리’(발병지수 차이: 0.68)는 대상 조직에서 Fol에 대한 반응의 차이가 있을 것이라고 판단된다. 본 실험에서 확립한 기내검정법을 이용하여 저항성 품종으로 알려진 ‘Oryun’과 ‘Connecticut king’을 검정해본 결과 발병지수가 1.57, 1.97로서 저항성이 나타나는 것으로 확인된 바 기내검정법을 이용한 결과를 신뢰할 수 있다고 판단하였다.
토양 저항성 검정
구근부패병인 Fol균은 soil-borne으로서 기내검정법으로 얻어진 결과에 대한 정확한 판별을 위해서는 토양 접종을 통한 발병 결과와 비교 분석하여 실효성을 판가름하는 것이 반드시 필요하다. 기내검정법으로 최종 선발된 저항성 품종(‘Royal surprise’, ‘Red velvet’, ‘Pink pagoda’)과 민감성 품종(‘Petit pink’, ‘Marco polo’, ‘땅나리’)으로 토양 검정을 수행하였다. Fol균의 토양 접종 후 병의 진행을 14일 이상 살펴본 결과, ‘Royal surprise’, ‘Red velvet’, ‘Pink pagoda’는 인편의 황변을 비롯하여 구근이 부패되는 등의 증상이 약하게 나타났으나 ‘Petit pink’, ‘Marco polo’, ‘땅나리’는 접종 후 4일 째 되는 날부터 부패 증상이 나타나기 시작하였고, 특히 14일 후 ‘Marco polo’와 ‘땅나리’는 구근이 완전히 부패되었고 ‘Petit pink’ 또한 부패 증상이 강하게 나타남을 확인하였다(Fig. 5). 토양검정 분석에 이용한 저항성, 민감성 품종 접종 결과 95% 유의수준을 만족함으로써 저항성, 민감성 품종 간의 저항성 차이가 나타나는 것으로 판단하였다. 이로써, 기내검정에 의하여 판별된 백합 품종들의 구근부패병 저항성정도가 토양 검정에서도 동일하게 재현되는 것을 확인하였고, 따라서 본 연구에서 확립한 기내검정법이 백합의 구근부패병 저항성 품종을 간편하고 신속하게 선발하는데 적용될 수 있을 것으로 보여진다. Lee et al.(2011)도 Fusarium fujikuroi CF283 접종에 의한 벼 저항성 품종 선별을 위하여 기내유묘검정법과 포장저항성 검정법을 비교한 결과 유사한 경향을 나타내었다고 보고하였다.
이상의 실험 결과를 종합하여, 백합 구근부패병의 저항성 정도를 검정하는 기내검정법을 제시하고자 한다. 이 방법은 PDA 배지에서 25°C, 암조건으로 6일 동안 배양한 Fol 균의 포자를 1.0 × 104spores・mL-1의 농도로 멸균수에 현탁하여 백합의 잎 절편체에 25°C, 암조건으로 22시간 동안 침지 접종한 후 0.6% 한천배지에 치상하고 7일 동안 관찰한 결과 나타나는 발병 정도에 의해 저항성 정도를 확인하는 것이다.